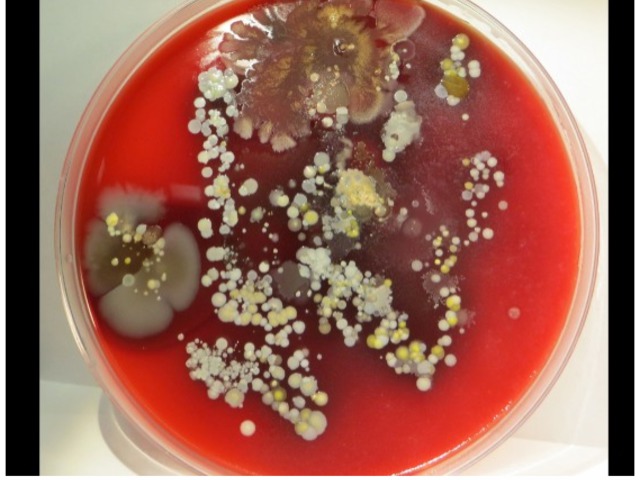

Az elmúlt hónapok során hatalmas fordulat következett be a vezető jegybankok irányadó kamatainak várható alakulásával kapcsolatban. 2018 második ...
Facebook vagy Google – melyik az igaz(i)?
Hal Variannak, a Google vezető közgazdászának az ábrája volt előttem. Varian nevével utoljára az egyetem alatt találkoztam, de be kell ismernem, ...
A sikeres befektető projekt
Amihez Mel Gibsonnak egy fürdőkádba esett hajszárító kellett, ahhoz nekünk elég lehet egy kérdőíves felmérés. Míg ugyanis a Mi kell a nőnek? ...
Amikor minden relatív – mi lesz a tőzsdékkel idén?
A tőkepiacon nem az abszolút számok számítanak, nem az önmagukban vett profitok és növekedési mutatók, hanem a relatívak. A jelenség évek óta ...
Big data és a tőzsdék: csodaszer vagy high-tech horoszkóp?
Elsősorban a bal szívkamrán múlik a dolog. Persze a túl kicsi lép vagy a túl hangos zihálás sem jó jel, de a legerősebb indikátor mégis csak a ...
Tuti tipp 2019-re: fektess tanárba!
Az USA jövő generációit a legjobbak helyett egyre inkább a leggyengébbek tanították. Legalábbis ez olvasható ki azokból a számokból, melyeket ...
Váratlan forinterősödés, kutyaszorítóban a jegybank
A devizaárfolyamok mozgása mindig váratlan, az elemzői előrejelzéseknek nem sok értelmük van, általában nem az szokott történni, amit a ...
Befektető vagy? Akkor mit nézel?!
Nem húzom az időt, mutatok gyorsan egy képet, ami több ezer ember életét mentette meg. Bocs, nem lesz túl gusztusos.

A kórházi fertőzések az ...
Tőzsdei naptárhatás: erős évkezdet, erős év?
Az idegtépő decembert követően az új év egyelőre emelkedést hozott az amerikai részvénypiacon (anélkül persze, hogy az év végi zuhanást ...
F.u.r.a. emberek
Nyugati, jól képzett, ipari és demokratikus társadalom tagja, illetve nem utolsó sorban jómódú. Angol mozaikszóval: W.E.I.R.D. (western, educated, ...